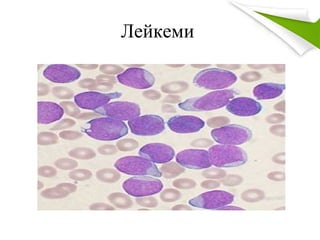
Лейкеми

Recommended
PPTX
Hamar daivar hondiin arhag urevsel
PPTX
PPTX
PPTX
зүрх том судасны дүрс оношлогоо
DOCX
Цээжний гялтанд шингэн хуралдах
PPTX
тархи нугасны-шингэний-өөрчлөлт
PPTX
нойр булчирхайн хорт хавдар
PPTX
аалзавчийн доорх цус харвалт
PPTX
PPTX
Перитонит peritonitis гяльтан хальсны үрэвсэл
PPTX
PPTX
таталтын үед үзүүлэх яаралтай тусламж
PPTX
ходоод,дээрх гэдэсний шархлаа өвчин
PPTX
PPTX
Amisgal lecture 20146.11.13
PPTX
PPTX
PPT
диатез, рахит, тураал, цу с багадалт 2013 д.м
PPTX
PPTX
Шархлаат колит & Кроны өвчин
PPTX
бэлгийн булчирхайн эмгэгүүд
PPTX
Kidney cancer бөөрний хавдар
PPTX
PPTX
PPTX
PPTX
PPTX
Мухар олгойн цочмог үрэвсэл
PPT
Артерийн гипертензийн ялган оношлогоо, эмчилгээ
PPTX
PPTX
More Related Content
PPTX
Hamar daivar hondiin arhag urevsel
PPTX
PPTX
PPTX
зүрх том судасны дүрс оношлогоо
DOCX
Цээжний гялтанд шингэн хуралдах
PPTX
тархи нугасны-шингэний-өөрчлөлт
PPTX
нойр булчирхайн хорт хавдар
PPTX
аалзавчийн доорх цус харвалт
What's hot
PPTX
PPTX
Перитонит peritonitis гяльтан хальсны үрэвсэл
PPTX
PPTX
таталтын үед үзүүлэх яаралтай тусламж
PPTX
ходоод,дээрх гэдэсний шархлаа өвчин
PPTX
PPTX
Amisgal lecture 20146.11.13
PPTX
PPTX
PPT
диатез, рахит, тураал, цу с багадалт 2013 д.м
PPTX
PPTX
Шархлаат колит & Кроны өвчин
PPTX
бэлгийн булчирхайн эмгэгүүд
PPTX
Kidney cancer бөөрний хавдар
PPTX
PPTX
PPTX
PPTX
PPTX
Мухар олгойн цочмог үрэвсэл
PPT
Артерийн гипертензийн ялган оношлогоо, эмчилгээ
Viewers also liked
PPTX
PPTX
PPT
лейкоцитоз, лейкопенія, лейкоз
PPTX
DOCX
PPTX
дулааны шалтгаант Цус задралын цус багадалт
PPTX
PPTX
PPT
B12 фолийн хүчлийн дутагдлын анеми ppt
PPT
PPTX
PPT
PPT
PPTX
PPTX
PPTX
PPTX
PPTX
PPTX
PPTX
Similar to Acute leukemia
DOCX
DOCX
PPTX
умайн хүзүүний хорт хавдар
PPTX
Pancreatic cancer Нойр булчирхайн хорт хавдар
PPTX
PPT
DOCX
PPTX
Сүрьеэгийн менингит---------------------
PPTX
PPTX
PPTX
Osteomyelit symptoms and categories
PPTX
уушигны завсрын эдийн өвчнүүд
PPTX
PPTX
PPTX
DOCX
PPT
Ходоодны хавдар ( Gastric cancer )
DOCX
PPTX
Мэдрэлийн системийн халдварын шалтгаант өвчнүүд
PPTX
More from Анагаахын Шинжлэх Ухааны Үндэсний Их Сургууль
PPT
PPT
PPTX
PDF
PPTX
PDF
цус алдалтын үед авах арга хэмжээ
PPTX
PPTX
PPTX
PPTX
PPTX
төрөлтийн 3- р үеийн физиологи, төрлөгийн гэмтэл
PPTX
2 р баг хэвлийн байршил зүйн анатоми
PPTX
PPTX
бодисын солилцооны хямрал
PPTX
гэмтлийн үеийн суурь тусламж
PPTX
PPT
PPT
Chronic lymphocytic leukemia
PPTX
PPTX
Acute leukemia 1. 2. Тодорхойлолт
• Гемобластоз- Цус төлжүүлэх эрхтэн
системийн хорт хавдар
• Хавдрын эсүүд анхдагчаар ясны улаан
чөмгөнд үүсч,үржин олширч цаашид захын
цус, дэлүү, тунгалгийн зангилаа болон
бусад эд эрхтэнд нэвчин тухайн эрхтний
үйл ажиллагааны дутагдалд хүргэдэг бүлэг
эмгэгийг Лейкеми гэнэ.
3. 4. Ангилал
Хурц лейкоз
• Цус төлжилтийн 4 ба
түүнээс дээших
ангийн эсүүдээс
гаралтай
Архаг лейкоз
• Цус төлжилтийн 5,6
ангийн эсүүд болох
ялгаран хөнжил нь
явагдсан нас бие
гүйцсэн эсүүдээс
гаралтай
6. 7. ХМЛ- ангилал (FAB)
• М0- ялгаран хөнжил багатай ХМЛ
• М1- бласт эсүүд нь боловсроогүй ХМЛ
• М2- бласт эсүүд нь боловсорсон ХМЛ
• М3- хурц промиелоцитын лейкеми
• М3v- хпл-н бага мөхлөгт хэлбэр
• М4- хурц миеломонобластын лейкеми
• М5- хурц монобластын лейкеми
• М6- хурц эритролейкеми
• М7- хурц мегакариобластын лейкеми
8. ХЛЛ- ангилал (FAB)
• L1- жижиг мономорфик хэлбэр- бласт эсийн хэмжээ
жижиг, ганцхан ялгарч харагдахгүй бөөмхөнтэй, бөөмийн
хэлбэр зөв дугуй байна
• L2- том гетерогеник хэлбэр- бласт эсийн хэмжээ том, олон
тооны тод ялгарч харагдах бөөмхөнтэй, бөөмийн хэлбэр
зөв биш шахагдсан байдалтай байна
• L3- буркитт эсийн хэлбэр- бласт эсийн хэмжээ том, илт
суурилаг цитоплазмтай, цитоплазм дотроо ваколиудтай
10. Шалтгаан
• Өвчтөний дотоод нөхцөл
- удамшлын
- хромосомын төрөлхийн гэмтэл, эсийн
онкоген идэврижих
-дархлалын хомсдол
• Гадаад орчны нөлөө
- ионжуулах туяа
- химийн бодис, эм
- вирус
11. Эмгэг жам
• Клоны онол
шалтгаан,
хүчин
зүйлийн
нөлөөгөөр
эсийн ДНХ,
генийн
аппаратын
гэмтэл
Эх эсийн
мутаци
Эсийн онкогены
бүтэц,
зохицуулга
алдагдана
Эсүүд
эмгэгээр хэт
олшрох
Цус багадах
Халдварт
өртөх
Цус гоожих
13. Эмнэл зүй шинжүүд
• Буйлнаас цус шүүрэх
• Чөмөгт болон хэмт ясаар
өвдөх
• Амархан хөхрөлт үүсэх
• Удаан хугацаагаар цус
гоожих
• Ядарч сульдах
• Халуурах
• Үе мөчөөр өвдөх
• Халдварт өртөмхий болох
• Сарын тэмдэг алдагдах
• Хамраас цус гарах
• Анемийн шинжүүд илрэх
• Элэг, дэлүү, тунгалгийн
зангилаа томрох
• Жижиг цэгчилсэн
цусархаг тууралтууд
илрэх
• Амьсгал давчдах
• Буйл хөвсийж хавдах,
хөндүүрлэх
• Турах
21. Өвчний ид үед 5 үндсэн хам шигж
илэрнэ
• Гиперплазийн хам шинж
• Цусархагшлын хам шинж
• Анемийн хам шинж
• Хордлогын хам шинж
• Дархлаа дутлын хам шинж
22. 23. 24. Оношлогоо
• ЦДШ- нормо, гиперхромын анеми
- тромбоцитопени
- ретикулоцитопени
- лейкограммд бласт 5%-с их
- лейкемийн цонх
- нейтропени
- УЭТХ ихэссэн байна.
25. • Миелограммд: бласт 20 хувь-с их, улаан эс,
гранулоцит, мегакариоцитын эгнээний
эсүүдийн үүсэл дарангуйлагдаж эрс
цөөрсөн
• Иммунофенотипийн шинжилгээ: эсийн
гадаргуу дахь антигений эсрэг үүссэн
моноклональ эсрэг биеийг тодорхойлсноор
ХМЛ, ХЛЛ ялган оношлох ба М0,М6,М7
хэлбэрүүдийг баттай оношлоно.
26. Ялган оношлох моноклональ эсрэг
биеүүд
• Миелойд- анти-МПО, CD13, CD33,
CDw65, CD117
• B лимфойд- CD19, цитоплазмын CD22,
CD79a, CD10
• T лимфойд- цитоплазмын CD3, CD2,
CD7
27. Цитохими
AML ALL
• Myeloperoxidase + -
• Sudan Black + -
• Chloroactate estherase + -
• Nonespecifiv estherase + /M4,M5/ -
• Periodic acid-Schiff - /+ in M6/ +/40-60%/
• Acid phosphatase + /M4-M6/ + /T-ALL/
28. 30. 31. Цитохимийн урвалууд
• Миелопероксидаз MPO эсвэл хар суданы
• Гликоген PAS
Хэрэв гликогены урвал хэсэгхэн газарт
цөөхөн том толбо юм уу бижирмэг
байдалтай байвал ХЛЛ аль ч урвал
гарахгүй бол ялгагдахгүй ХЛ.
Гликогены урвал бластын цитоплазмд жижиг
диффуз байдалтай эсвэл пероксидаза урвал
тод байвал ХЛБЛ
32. • Молекул генийн шинжилгээ
PCR- урвуу транскиптаз полимеразын
гинжин урвал
FISH- флюоресцентийн эрлийзжүүлэх
хромосомын гажгууд өчүүхэн үлдэцийг
илүү мэдрэгээр илрүүлнэ
• Нугасны усны шинжилгээ
• X-Ray, CT
33. 34. Хими эмчилгээ
• 4 шаттай
1.Бүрэн засралд хүргэх Индукц эмчилгээ
ХМЛ- 7+3, 5+2 Ara-C, Даунорубицин
ХЛЛ- винкристин, преднизолон,
даунорубицин, аспарагиназа,
цмклофосфофамид
35. 2. Засралыг батжуулах
Консолидац
хавдрын хүндрэл, дахилт өгөх болон
эмэнд тэсвэртэй эсүүдийн үржих эрсдлийг
багасгах зорилгоор хийх ба 1 юмуу 2
эрчимжүүлсэн үе шатаар метотрексат
өндөр тунгаар, цитарабин, этопозид,
амсакрин, метаксантрон, идарубицин
зэргийг хавсран хэрэглэнэ.
36. 3. Барих эмчилгээ
• 6 МКП-г өдөр бүр, метотрексатыг 7 хоногт
1 удаа 2-3 жилийн турш, винкристинийг
судсаар, метотрексатыг тархи нугасны
шингэнд тодорхой давтамжтайгаар
хэрэглэнэ
37. 4. Нейролейкемигээс урьдчилан
сэргийлэх буюу эмчлэх
• Урьдчилан сэргийлж тархийг шарах ба
тархи нугасны шингэнд хатгалт хийн хими
эмчилгээг хийж эмчилгээг засралыг
батжуулах эрт үеийн эмчилгээтэй хамт
эхэлж барих эмчилгээний явцад мөн
үргэлжлүүлнэ.
38. • AML:-
• INDUCTION Chemotherapy – Anthracycline (Daunorubicin or idarubicin) + Cytarabine
• APL is treated with anthracycline plus all – trans – retinoic acid which achieves 90 – 95%
complete remission.
• Once remission is achieved, CONSOLIDATION & MAINTENANCE therapy are given.
• ALL:-
• INDUCTION – Prednisolone + Vincristine + L – asparaginase/Daunorubicin
• CNS prophylaxis – Intrathecal methotrexate or cranial irradiation
• CONSOLIDATION
• MAINTENANCE – Methotrexate & 6 Mercaptopurine
• SUPPORTIVE THERAPY:-
• Management of Tumor lysis syndrome
• Monitoring counts & if required blood transfusions
• Colony stimulating factors
• Empirical broad spectrum antibiotics
• Pneumocystis & fungal infection prophyulaxis.
• DEFINITIVE THERAPY:-
• Autologous or allogenic stem cell transplant
39. 40.